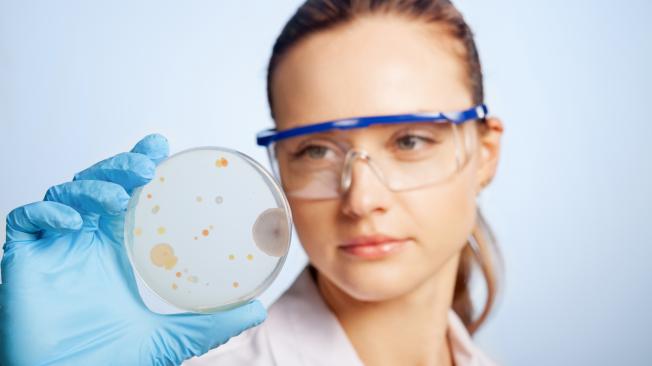

News
12/11/2019
DURA®care Liquid
DURA®care Liquid
En combinaison avec les produits Dold, la technologie antimicrobienne fournit un soutien précieux au niveau des mesures d’hygiène.
Cet additif fonctionnel pour revêtements intérieurs réduit sensiblement la prolifération des bactéries entre les cycles de nettoyage dans les hôpitaux, les établissements de soin, les organismes publics, mais également dans la cuisine et la salle de bain. La technologie DURA®care Liquid est conservée dans l’article pendant toute sa durée de vie, permettant un effet continu et durable. En fonction des conditions ambiantes, vous disposerez ainsi d’une surface DURA®care Liquid équipée d’une protection antimicrobienne pendant de nombreuses années.